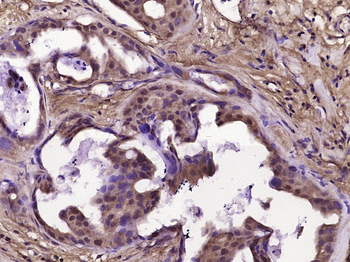
CDK1 Rabbit Polyclonal Antibody

You have no items in your shopping cart.
- Acid sphingomyelinase Rabbit Polyclonal Antibody [orb101555]Featured

FC, IF, IHC-Fr, IHC-P, WB
Human, Rat
Bovine, Canine, Mouse, Porcine, Rabbit
Rabbit
Polyclonal
Unconjugated
50 μl, 100 μl, 200 μl - CDK1 Rabbit Polyclonal Antibody [orb10352]Featured

IF, IHC-Fr, IHC-P, WB
Human, Mouse
Canine, Equine, Rat
Rabbit
Polyclonal
Unconjugated
50 μl, 100 μl, 200 μl - CNPase Rabbit Polyclonal Antibody [orb10429]Featured

IF, IHC-Fr, IHC-P, WB
Mouse, Rat
Bovine, Canine, Equine, Human, Rabbit
Rabbit
Polyclonal
Unconjugated
200 μl, 50 μl, 100 μl - ADAM17 Rabbit Polyclonal Antibody [orb4374]Featured

FC, ICC, IF, IHC-Fr, IHC-P, WB
Human, Mouse, Rat
Bovine, Canine, Porcine, Rabbit
Rabbit
Polyclonal
Unconjugated
200 μl, 50 μl, 100 μl - Featured

FC, ICC, IF, IHC-Fr, IHC-P, WB
Human, Mouse, Rat
Rabbit
Rabbit
Polyclonal
Unconjugated
50 μl, 100 μl, 200 μl - Featured

IF, IHC-Fr, IHC-P, WB
Mouse, Rat
Canine, Human
Rabbit
Polyclonal
Unconjugated
100 μl, 50 μl, 200 μl - Featured

ICC, IF, IHC-Fr, IHC-P, WB
Human, Mouse, Rat
Bovine, Canine, Equine, Rabbit
Rabbit
Polyclonal
Unconjugated
100 μl, 50 μl, 200 μl - IL-2 Rabbit Polyclonal Antibody [orb184296]Featured

IF, IHC-Fr, IHC-P, WB
Human, Mouse, Rat
Mouse, Rat
Rabbit
Polyclonal
Unconjugated
50 μl, 100 μl, 200 μl - NF-H Rabbit Polyclonal Antibody [orb11117]Featured

IF, IHC-Fr, IHC-P
Mouse, Rat
Human
Rabbit
Polyclonal
Unconjugated
50 μl, 100 μl - Nogo-A Recombinant Rabbit Monoclonal Antibody [orb1816973]Featured

ICC, WB
Human, Mouse
Human, Mouse
Rabbit
Recombinant
Unconjugated
100 μl, 50 μl